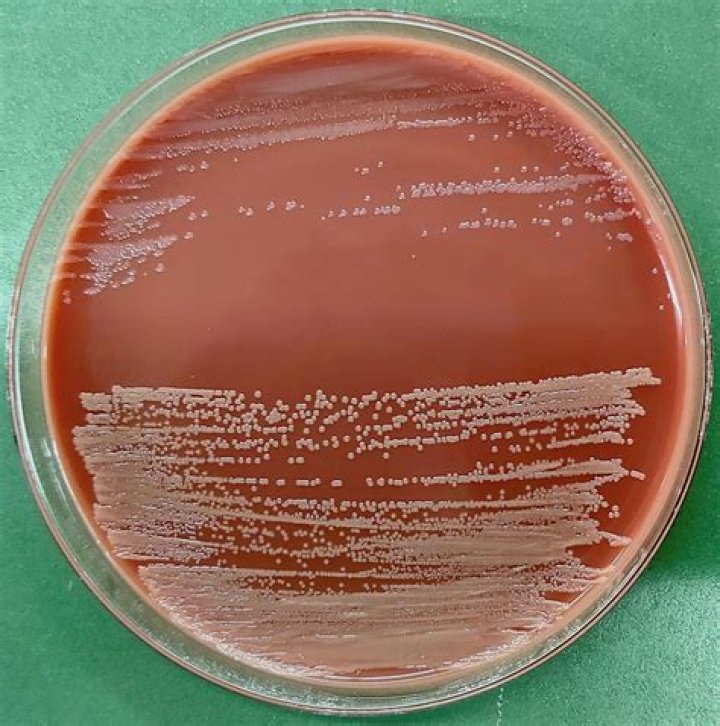

Does Neisseria gonorrhoeae grow on nutrient agar

Sarah Rodriguez
Published Mar 11, 2026
Ability to grow on nutrient agar is one of the criteria to differentiate commensal Neisseria spp. and M. catarrhalis
What agar does Neisseria gonorrhoeae grow on?
Culture for Neisseria gonorrhoeae is typically performed on media such as chocolate (cooked sheep’s blood) agar, Thayer-Martin, or GC medium incubated in a 5% CO2 atmosphere.
Would N gonorrhoeae grow on a Mac plate?
No growth was observed on MacConkey agar. The bacterium was positive for catalase, oxidase, and acid production from glucose but not maltose. It was identified, with 98% probability, as N.
Does Neisseria gonorrhoeae grow on MacConkey Agar?
Note: Neisseria does not grow on MacConkey. Note: Growth, but no fermentation of lactose. Colorless colonies, medium is slightly yellow due to the increased pH resulting from bacterial digestion of peptone in the medium.Does Neisseria gonorrhoeae grow on EMB agar?
While the plate on the right selectively only allows the bacteria Neisseria gonorrhoeae, to grow (white dots). Eosin methylene blue (EMB) that contains methylene blue – toxic to Gram-positive bacteria, allowing only the growth of Gram negative bacteria.
Does Neisseria meningitidis grow on blood agar?
N. meningitidis is a fastidious organism, which grows best at 35-37°C with ~5% CO2 (or in a candle-jar). It can grow on both a blood agar plate (BAP) and a chocolate agar plate (CAP).
Does Neisseria meningitidis grow on MacConkey agar?
They are positive for catalase production, cytochrome oxidase production, growth at 37°C and at room temperature (18 – 22°C) and growth on MacConkey agar.
Does Neisseria gonorrhoeae grow on chocolate agar?
Red blood cell lysis gives the medium a chocolate-brown coloration when prepared from which the agar gets its name. The most common bacterial pathogens that require this enriched medium for growth include Neisseria gonorrhoeae and Haemophilus species.Does Neisseria grow on chocolate agar?
Chocolate agar is used for growing fastidious respiratory bacteria, such as Haemophilus influenzae and Neisseria meningitidis. In addition, some of these bacteria, most notably H.
Can Haemophilus grow on blood agar?Haemophilus influenzae requires both factors X and V; accordingly, it grows on chocolate agar but not on blood agar (Fig. 30-2), although it may appear on a blood agar plate as tiny satellite colonies around the colonies of other bacteria that have lysed red blood cells.
Article first time published onWhat bacteria grows on nutrient agar?
Microorganisms need food, water and a suitable environment in order to survive and grow. Nutrient agar provides these resources for many types of microbes, from fungi like yeast and mold to common bacteria such as Streptococcus and Staphylococcus.
Can any Gram-positive bacteria grow on MacConkey Agar?
Gram-positive bacteria will not form any colonies on MacConkey medium.
Is LB agar selective or differential?
Blood Agar Plates It is an enriched, non-selective differential medium that supports growth of a variety of bacteria and can detect hemolytic activity of the microorganism.
What kind of media is nutrient agar?
Nutrient agar is a general-purpose media that is mostly used for routine culture or to ensure prolonged survival of microorganisms. It is one of the most important and commonly used non-selective media for the routine cultivation of microorganisms.
What grows VPN Agar?
It is used for culturing and primarily isolating pathogenic Neisseria bacteria, including Neisseria gonorrhoeae and Neisseria meningitidis, as the medium inhibits the growth of most other microorganisms.
Does Neisseria meningitidis endospores?
Neisseria meningitidis is a parasitic, aerobic, Gram-negative, non endospore forming, nonmotile (although piliated) , coccal bacterium that is responsible for causing meningitis, inflammation of the meninges layer covering the brain.
How do you differentiate Neisseria gonorrhoeae and Neisseria meningitidis?
N. gonorrhoea is kidney shaped with apposing ends concave. N. meningitidis is semicircular diplococcus with flat apposing ends.
Does Neisseria meningitidis Fimbriae?
Other virulence factors include a polysaccharide capsule which prevents host phagocytosis and aids in evasion of the host immune response; fimbriae mediate attachment of the bacterium to the epithelial cells of the nasopharynx.
Is Neisseria meningitidis aerobic or anaerobic?
The human pathogen Neisseria meningitidis is the major causative agent of bacterial meningitis. The organism is usually treated as a strict aerobe and is cultured under fully aerobic conditions in the laboratory.
Does Neisseria gonorrhoeae have a capsule?
gonorrhoeae does not have a capsule, it does express both lipooligosaccharide and O-linked glycoproteins. Neisseria gonorrhoeae also has the ability to scavenge host sialic acids, while several N. meningitidis serogroups can synthesise sialic acid.
Why does gonorrhea not grow on blood agar?
Neisseria gonorrhoeae are the most fastidious of the Neisseria species, require complex growth media and are highly susceptible to toxic substnces (e.g., fatty acids). Gonococci are not able to grow on common blood agar.
What grows on a blood agar plate?
Blood Agar is used to grow a wide range of pathogens particularly those that are more difficult to grow such as Haemophilus influenzae, Streptococcus pneumoniae and Neisseria species. It is also required to detect and differentiate haemolytic bacteria, especially Streptococcus species.
Why does Haemophilus influenzae grow on chocolate agar?
Growth occurs on a CAP because NAD is released from the blood during the heating process of chocolate agar preparation (the heating process also inactivates growth inhibitors) and hemin is available from non-hemolyzed as well as hemolyzed blood cells. Alternatively, NAD can be included as a component of liquid H.
Does Haemophilus influenzae grow on MacConkey agar?
Haemophilus spp. do not grow on MacConkey agar. Haemophilus influenzae has been shown to cause invasive infection such as meningitis and there is direct spread from water droplets from the upper respiratory tract of infected individuals. The development of the H. influenza type B vaccine has decreased mortality.
Is Haemophilus aerobic?
All Haemophilus are gram-negative, aerobic or facultative anaerobic and nonmotile and require a growth factor that is found in blood. They are minute in size, H. influenzae measuring 0.3 micrometre across and up to 2 micrometres long.
What factor does blood agar contain?
Blood agar is a type of growth medium with trypticase soy agar base enriched with 5% sheep blood. Beta hemolysis in sheep blood agar. Blood agar consists of a base containing a protein source (e.g. Tryptones), soybean protein digest, sodium chloride (NaCl), agar, and 5% sheep blood.
What nutrients does nutrient agar provide?
Nutrient agar is a general purpose medium supporting growth of a wide range of non-fastidious organisms. It typically contains (mass/volume): 0.5% peptone – this provides organic nitrogen. 0.3% beef extract/yeast extract – the water-soluble content of these contribute vitamins, carbohydrates, nitrogen, and salts.
Can fungi grow on nutrient agar?
Nutrient Agar is a general purpose, nutrient medium used for the cultivation of microbes supporting growth of a wide range of non-fastidious organisms. Nutrient agar is popular because it can grow a variety of types of bacteria and fungi, and contains many nutrients needed for the bacterial growth.
Can nutrient agar grow anaerobic bacteria?
Media: Anaerobic Blood Agar is the best media choice for growing obligate anaerobes. Fresh prepared Nutrient Agar, Tryptic Soy Agar (Soybean Casein Digest Agar), and Standard Methods Agar (Plate Count Agar) are appropriate alternatives for some Clostridium species with an additional period (24 hours) of incubation.
Does Campylobacter jejuni grow on MacConkey agar?
Only 33% of the Campylobacter spp. tested could grow on MacConkey medium indicating its relatively poor selectivity for Campylobacter spp. The KB and CAT media were similar as regards their selectivity for Campylobacter spp. The Gram-negative bacteria other than Campylobacter spp.
Does Pseudomonas aeruginosa grow on MacConkey agar?
Apart from the media mentioned above, Pseudomonas aeruginosa can also be grown in MacConkey agar (a bacterial culture medium commonly used to grow lactose fermenting bacteria). … In MacConkey agar, Pseudomonas aeruginosa forms flat and smooth colonies that are between 2 and 3mm in diameter.



